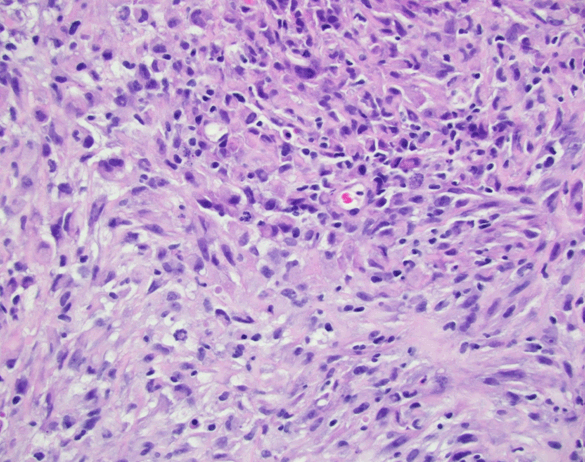

|

|
 |
|
Case Report
| ||||||
| 1,25-Dihydroxyvitamin D-mediated hypercalcemia in a patient with malignancy without lymphoma | ||||||
| Katie Mastoris1, Sarah Park1, Vasudev Magaji2 | ||||||
|
1D.O, Department of Medicine, Lehigh Valley Health Network, Allentown PA.
2MD, Division of Endocrinology, Department of Medicine, Lehigh Valley Health Network, Allentown PA. | ||||||
| ||||||
|
[HTML Abstract]
[PDF Full Text]
[Print This Article]
[Similar article in Pumed] [Similar article in Google Scholar] 
|
| How to cite this article |
| Mastoris K, Park S, Magaji V. 1,25-Dihydroxyvitamin D-mediated hypercalcemia in a patient with malignancy without lymphoma. Int J Case Rep Images 2015;6(7):403–406. |
|
Abstract
|
|
Introduction:
Hypercalcemia resulting from calcium homeostasis imbalance is seen in one-third of malignancies. Solid malignancies cause hypercalcemia from high parathyroid hormone-related peptide (PTHrP) and, infrequently, from osteolytic cytokines. Excessive 1, 25-dihydroxyvitamin D, seen mostly in lymphoma, causes hypercalcemia by 1-alpha-hydroxylation of 25-hydroxyvitamin D. This mechanism has also been reported in a few cases of dysgerminoma, myofibroblastic tumors, and gastrointestinal stromal tumors.
Case Report: We present an unusual case of 1,25-dihydroxyvitamin D mediated hypercalcemia in a 62-year-old male with colonic adenocarcinoma and mesothelioma. Conclusion: This case emphasizes that elevated 1,25-dihydroxyvitamin D may be a hypercalcemia etiology in non-lymphoma malignancies and should to be considered when workup for elevated PTHrP and osteolytic hypercalcemia is negative. | |
|
Keywords:
Adenocarcinoma, 1-alpha-hydroxylase, 1,25-dihydroxyvitamin D, Hypercalcemia, Mesothelioma
| |
|
Introduction
| ||||||
|
Hypercalcemia is one of the most common endocrine and electrolyte derangements seen in malignancies. Paraneoplastic mechanisms leading to hypercalcemia include tumor production of parathyroid hormone-related peptide (PTHrP), osteolytic bone lesions, ectopic parathyroid hormone (PTH) production, or elevated 1,25 dihydroxyvitamin D [1,25(OH)2D] levels through activation of an extrarenal 1-alpha-hydroxylase. Hypercalcemia from elevated 1,25(OH)2D is commonly seen in patients with lymphoma [1]. We report a case of 1,25(OH)2D mediated hypercalcemia in a patient with 2 primary malignancies: adenocarcinoma of the rectum and epitheloid mesothelioma. | ||||||
|
Case Report
| ||||||
|
A 62-year-old male presented to his primary care physician's office with one-month duration of difficulty moving bowels, bloating, and abdominal pain. Abdominal computed tomography (CT) scan revealed rectal thickening concerning for malignancy with metastatic lymphadenopathy and a right upper quadrant 20 cm mass centered in the left lobe of the liver. Biopsy of sigmoid colon showed invasive moderately differentiated adenocarcinoma (Figure 1). Pre-colonoscopy laboratory evaluation at this visit demonstrated an elevated calcium level (Table 1). Five days following colonoscopy, the patient presented to the emergency department with right lower extremity cellulitis leading to hospitalization and septicemia. Due to concern for liver abscess, the liver mass was biopsied. Pathology showed high-grade epithelioid mesothelioma (Figure 2). During the hospitalization, his calcium levels rose (Table 1) and workup for the etiology of hypercalcemia began (Table 2). There was no evidence of osteolytic lesions on imaging, serum and urine electrophoresis were negative, and thyroid-stimulating hormone was within normal limits. There was also no evidence of granulomatous disease or evidence of granulomatous infection on imaging studies. Bisphosphonate administration brought the patient's calcium level to within normal range (Table 1). His hospital course continued due to septicemia and renal failure requiring dialysis. He was eventually transferred intensive care unit because of hypotension and septic shock from Escherichia coli bacteremia secondary to right leg cellulitis. Despite being on 3 vasopressors, antibiotics, and continuous renal replacement therapy, his condition deteriorated and patient died on comfort measures. | ||||||
| ||||||
|
| ||||||
| ||||||
| ||||||
|
Discussion
| ||||||
|
Hypercalcemia resulting from calcium homeostasis imbalance is seen in one-third of malignancies and commonly occurs through increased synthesis of parathyroid hormone-related peptide (PTHrP) or metastatic osteolytic bone lesions. Our patient's elevated calcium level occurred through excessive 1,25(OH)2D levels as evident by normal PTHrP, lack of osteolytic lesions, low PTH and elevated 1,25(OH)2D. Elevated 1,25(OH)2D results in hypercalcemia through increased calcium absorption in the gastrointestinal tract and by promoting osteoclast differentiation and increased activity. Elevated 1,25(OH)2D mediated hypercalcemia has been established in granulomatous diseases and lymphomas. This mechanism occurs through elevated extra renal hydroxylation of 25-hydroxyvitamin D. Normally, regulation of 1,25(OH)2D levels occurs in the proximal convoluted tubules of the kidney through hydroxylation of 25-hydroxyvitamin D by the 1-alpha-hydroxylase enzyme. Regulation of this enzyme by the parathyroid hormone (PTH) and calcitriol results in normal calcium levels. Extra-renal 1-alpha-hydroxylase, however, is insensitive to normal feedback mechanisms, which leads to uncontrolled hypercalcemia. Extra-renal 1-alpha-hydroxylase has been established in tumor adjacent tissue macrophages in lymphoma patients [1] with very few cases reporting extra-renal 1-alpha hydroxylase or elevation of 1,25(OH)2D as the cause of hypercalcemia in other malignancies. Among these neoplasms, dysgerminomas of the ovary leading to hypercalcemia have been reported [2]. Resection of the dysgerminoma resulted in normalization of serum calcium and 1,25(OH)2D. Similarly, one patient with pleural mesothelioma had increased calcium levels due to elevated 1,25(OH)2D which again normalized after resection [3]. A case of inflammatory myofibroblastic tumor on surgical pathology associated with hypercalcemia and 1,25(OH)2D elevation [4] showed abundant messenger RNA (mRNA) encoding for 1-alpha-hydroxylase in the tumoral tissue. While in a case of gastrointestinal stromal tumor with 1,25(OH)2D-associated hypercalcemia, the patient transiently responded to tyrosine kinase inhibitor and bisphosphonates [5]. Our case demonstrates the rare occurrence of 1,25(OH)2D-mediated hypercalcemia in a patient with mesothelioma and colon cancer. Moreover, it shows two different malignancies possibly associated with this mechanism. There has only been one prior reported case of pleural mesothelioma associated with hypercalcemia and 1,25(OH)2D elevation [4]. Interestingly, there is no adenomatous colon cancer case report of 1,25(OH)2D-mediated hypercalcemia despite ex vivo upregulation of mRNA encoding for 1-alpha-hydroxylase being described in colon cancer [6] [7]. Due to our patient's underlying septicemia and deterioration, we were unable to explore which malignancy caused the elevated levels of 1,25(OH)2D. | ||||||
|
Conclusion
| ||||||
|
We recommend considering further investigation in patients with hypercalcemia when workup for elevated PTHrP and osteolytic hypercalcemia is negative, as elevated 1,25(OH)2D could be a hypercalcemia etiology in non-lymphoma malignancies. | ||||||
|
References
| ||||||
| ||||||
|
[HTML Abstract]
[PDF Full Text]
|
|
Author Contributions
Katie Mastoris – Substantial contributions to conception and design, Acquisition of data, Analysis and interpretation of data, Drafting the article, Revising it critically for important intellectual content, Final approval of the version to be published Sarah Park – Substantial contribution to design, acquisition of data, Analysis and interpretation of data, Drafting the article, Final approval of the version to be published Vasudev Magaji – Substantial contribution to design, acquisition of data, Analysis and interpretation of data, Revising the article critically for important intellectual content, Final approval of the version to be published |
|
Guarantor of submission
The corresponding author is the guarantor of submission. |
|
Source of support
None |
|
Conflict of interest
Authors declare no conflict of interest. |
|
Copyright
© 2015 Katie Mastoris et al. This article is distributed under the terms of Creative Commons Attribution License which permits unrestricted use, distribution and reproduction in any medium provided the original author(s) and original publisher are properly credited. Please see the copyright policy on the journal website for more information. |
|
|